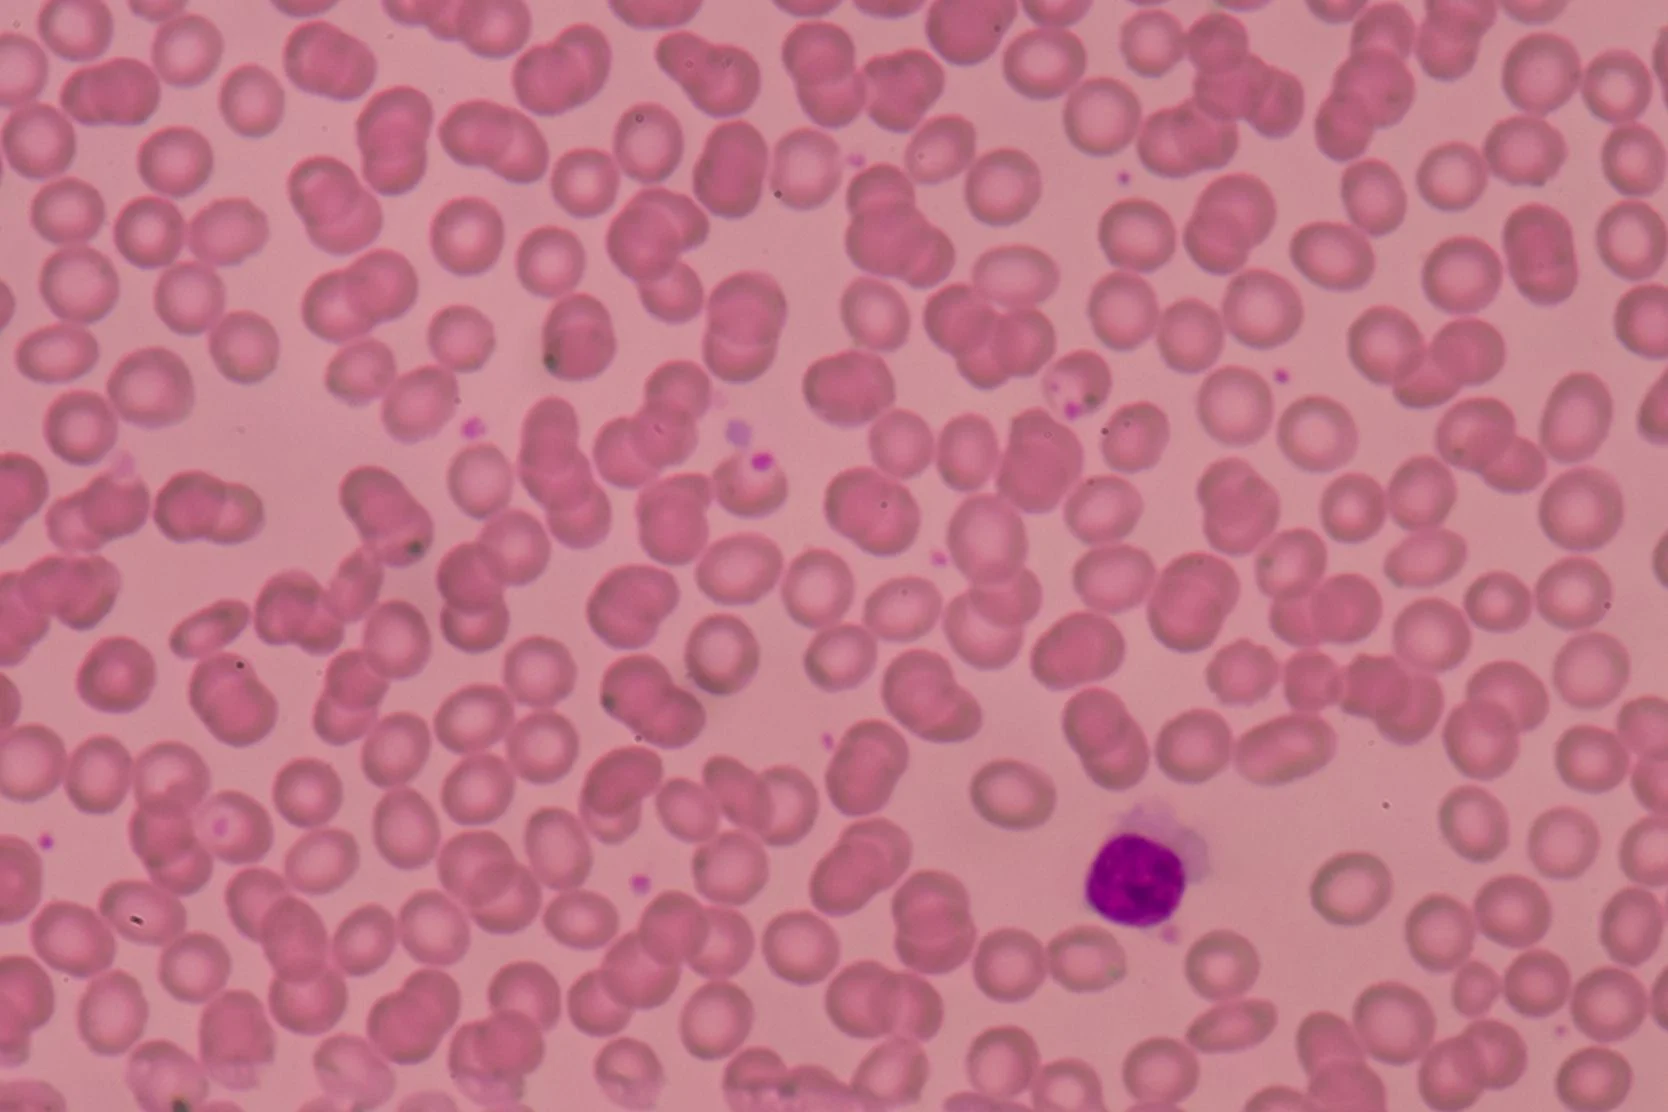

Autologous Transplant Guide: Introduction
Overview
A bone marrow transplant is the replacement of diseased or damaged bone marrow cells with new bone marrow cells that have been stored, frozen or obtained from a bone marrow donor. The administration of bone marrow usually occurs after a patient has received high-dose chemotherapy or radiation.
In essence, a bone marrow transplant uses very high doses of therapy in attempt to cure the cancer. When these higher doses are used to kill the cancer cells, the normal bone marrow cells will also be destroyed. The new bone marrow cells are infused after the toxic effects of the chemotherapy or radiation have cleared, and these cells will re-create a healthy bone marrow.
The procedure has been used successfully to treat a variety of cancer types, including leukemia, lymphoma, multiple myeloma, myelodysplasia and solid tumors, such as testicular cancer or breast cancer. It has also been used as a therapy for disorders like aplastic anemia, which are associated with bone marrow failure.
Bone Marrow and Stem Cells
Bone marrow is the spongy tissue inside bones that produces the different types of blood cells, including:
- White blood cells, which fight infection
- Red blood cells, which carry oxygen to and remove waste products from organs and tissues
- Platelets, which enable the blood to clot
The cells in the bone marrow that develop into all of the different types of blood cells listed above are called stem cells. These are the important cells that are transferred during bone marrow or stem cell transplantation.
Stem cells are found predominantly in the bone marrow but occasionally can be stimulated to travel out into the blood. When the stem cells are collected from the hip bone by performing many bone marrow aspirations (usually performed in the operating room), the transplant procedure is called a bone marrow transplant. When the stem cells are collected from the blood, after stimulating the stem cells with a hormone called G-CSF, the transplant is called a peripheral blood stem cell transplant. Currently, most transplant procedures involve collecting stem cells from the peripheral blood.
When bone marrow or blood stem cells are infused into the recipient, they are administered through an intravenous catheter or central venous catheter, just like a blood transfusion. The stem cells are not administered directly back into the bone, but travel to the bones from the blood stream.
Transplant Types and Results
Advances in the treatment of cancer and improvements in supportive care over the past 10 years have improved the results and tolerability of bone marrow transplantation. However, having a bone marrow transplant remains a dangerous and difficult procedure.
There are two main types of bone marrow transplants: allogeneic and autologous. For autologous transplantation, the patient receives his or her own bone marrow or stem cells that were collected and frozen before admission for high-dose chemotherapy or radiation. For allogeneic transplantation, the patient receives bone marrow or stem cells from a donor who may or may not be a relative.
Allogeneic transplants are significantly more dangerous and require more intensive follow-up after the transplant procedure. Identical twin allogeneic transplants are called syngeneic transplants.
Continue Reading
- Next: The BMT Team
Return to the Autologous Transplant Guide Index:
UCSF Health medical specialists have reviewed this information. It is for educational purposes only and is not intended to replace the advice of your doctor or other health care provider. We encourage you to discuss any questions or concerns you may have with your provider.